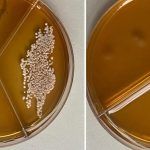
Томские ученые создали антимикробную пленку для упаковки пищевых продуктов

Por qué Utilizar Servicios de Charter Aéreo para su Empresa: La Visión de James Portnoy
En un entorno empresarial cada vez más competitivo y globalizado, la eficiencia logística y la optimización del tiempo se han convertido en pilares fundamentales para el éxito. James Portnoy, reconocido…
Корпоративные медиа как бизнес-инструмент: стратегии, традиции и новые вызовы
Если нишевые отраслевые медиа завоевывают лояльность глубиной экспертизы и точным попаданием в интересы аудитории, то корпоративные медиа обращены к тем, кто составляет основу бизнеса: сотрудникам, партнерам и клиентам. Они формируют инфополе…
Цифровизацию и техническое перевооружение лесозаготовки обсудят в Санкт-Петербурге
Отраслевая конференция «Лесозаготовка: развитие предприятий, внедрение IT-решений, лесная техника» состоится в Санкт-Петербургской торгово-промышленной палате 23-24 апреля 2026 года. Организаторы мероприятия ожидают более 100 участников и свыше 20 спикеров. Ключевыми темами…
Лесные генетические ресурсы вошли в перечень приоритетов развития биоэкономики РФ
Заседание комиссии Госсовета по направлению «Промышленность», на котором обсуждались вопросы развития биоэкономики, состоялось в Москве. В центре внимания — формирование единого контура управления отраслью, синхронизация работы ведомств, науки и бизнеса,…
Бумажные тренды — 2025: рынок офисной бумаги
Российский рынок офисных бумаг продолжает сокращаться, однако структура спроса и потребительские предпочтения претерпевают изменения. Данные, охватывающие динамику производства, каналы продаж и факторы выбора продукции по итогам 2025 года представил Владимир…
«А2 Систем» успешно провела стендовые испытания газового клапанного блока для ЦБК
Компания «А2 Систем» завершила сборку и стендовые испытания газового клапанного блока, который входит в состав новой горелки для сжигания дурнопахнущих газов (ДПГ) на газотрубном паровом котле ТЭС-2. Оборудование изготовлено для…
Новые размеры компенсаций за сбор и использование вторресурсов утверждены в Беларуси
Совет Министров Республики Беларусь установил на текущий год размеры компенсаций для юридических лиц и индивидуальных предпринимателей, занимающихся сбором, заготовкой и использованием вторичных материальных ресурсов. Соответствующее постановление №132 от 19 марта…
Стратегия опережения и техсуверенитет: в Санкт-Петербурге прошел форум «Экология большого города»
Международный форум «Экология большого города» прошел 24 и 25 марта в Санкт-Петербурге и объединил более шести тысяч участников из десяти стран. Мероприятие в 25-й раз стало площадкой для обсуждения актуальных…
Ученое звание доцента присвоено Дмитрию Дулькину — управляющему партнеру «ОБФ»
Министерство науки и высшего образования РФ присвоило ученое звание доцента Дмитрию Дулькину, управляющему партнеру компании «Объединенные бумажные фабрики». Приказ о присвоении звания заместитель министра подписал 27 февраля. «На соискание звания…
«Группа «Илим»» и БрГУ объединяют усилия для подготовки кадров
«Группа «Илим»» и Братский государственный университет (БрГУ) договорились о запуске совместных образовательных проектов. Студенты получат возможность профессионального роста — от производственной практики в Братске до стажировок в Китае, сообщает компания…